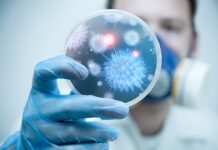
Korona virüsü evrim geçirdikçe belirtileri de değişiyor; yeni baskın belirti, Hipozmi

Ana Sayfa 2022
Yıllık Arşiv: 2022
Elon Musk’ın yaptığı ‘CEO’luk görevini bırakmalı mıyım?’ anketi sonuçlandı! % 57.5…
Elon Musk'ın yaptığı 'CEO’luk görevini bırakmalı mıyım?' anketi sonuçlandı! % 57.5...
Twitter’ı satın alma süreci ve Twitter’ı yönetme biçimiyle tepkilerin odağında olan şirketin yeni sahibi ve...
Yazar Aydın Ilgaz hayatını kaybetti!
Yazar Aydın Ilgaz hayatını kaybetti!
Türkçe edebiyatın önemli isimlerinden yazar ve yayıncı Aydın Ilgaz İstanbul’da yaşamını yitirdi.
Sınıfın Efsanesi adlı kitabın da yazarı olan Aydın Ilgaz, Rıfat...
⚽Türkiye Kupası’nda 5. tur heyecanı yarın başlıyor
⚽Türkiye Kupası'nda 5. tur heyecanı yarın start alıyor
Futbolda Ziraat Türkiye Kupası'nın 5. eleme turu mücadelesi yarın başlayacak.
Türkiye Futbol Federasyonundan yapılan açıklamaya göre, tek maç...
Sokaktan çipi olmayan hayvan sahiplenebilir miyim? İşte cevabı…
Sokaktan çipi olmayan hayvan sahiplenebilir miyim? İşte cevabı...
Kedi, köpek ve gelinciklerin mikroçip takılarak kayıt altına alınması süresi yılbaşında dolacak.
Yılbaşından sonra sokaktan sahiplenilen kimliksiz hayvanlar,...
Korona virüsü evrim geçirdikçe belirtileri de değişiyor; yeni baskın belirti, Hipozmi
Korona virüsü evrim geçirdikçe belirtileri de değişiyor; yeni baskın belirti, Hipozmi
İngiltere’de yapılan anket ve araştırma sonuçlarına göre Covid-19’un da en belirgin belirtileri şekil değiştirdi.
Bir...
Bir eksik vardı, tamamlandı. İşte Lionel Messi’nin kazandığı kupalar
Bir eksik vardı, tamamlandı. İşte Lionel Messi'nin kazandığı kupalar
2022 Dünya Kupası'nda Arjantin zafere ulaşırken Lionel Messi de kariyerinin tek ve en büyük eksiğini gidermiş...
Görenler şaşkına döndü. Su kanalında çok sayıda eşek başı ve kemikleri bulundu!
Görenler şaşkına döndü. Su kanalında çok sayıda eşek başı ve kemikleri bulundu!
Adana'nın merkez Yüreğir ilçesi, atık su kanalında, bir kısmı çuvallara doldurulmuş çok sayıda...
🏀Fenerbahçe Beko, yeni transferini açıkladı; Kostas Antetokounmpo Fenerbahçe Beko’da
🏀Fenerbahçe Beko, yeni transferini açıkladı; Kostas Antetokounmpo Fenerbahçe Beko'da
Fenerbahçe Beko, Kostas Antetokounmpo'yla sezon sonuna kadar sözleşme imzalandığını açıkladı.
Sarı-lacivertli takımdan yapılan açıklamada Kostas Antetokounmpo ile sezon...
Twitter’da şimdi de URL yasağı!
Twitter'da şimdi de URL yasağı!
Twitter'ın sahibi Elon Musk, Facebook, Instagram ve diğer önde gelen sosyal medya platformlarının bağlantı adreslerinin kullanılmasını yasakladı.
Amerikalı milyarder Elon Musk,...
2021 Nüfus ve Konut Sayımı verileri açıklandı; Kadınların yüzde 4,2’si̇ okuma yazma bi̇lmi̇yor
2021 Nüfus ve Konut Sayımı verileri açıklandı; Kadınların yüzde 4,2’si̇ okuma yazma bi̇lmi̇yor
Türkiye İstatistik Kurumu (TÜİK) Nüfus ve Konut Sayımı, 2021 verisini açıkladı.
Buna göre,...